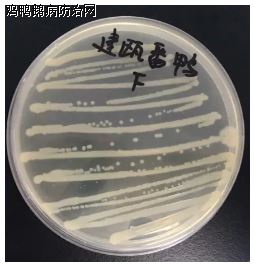
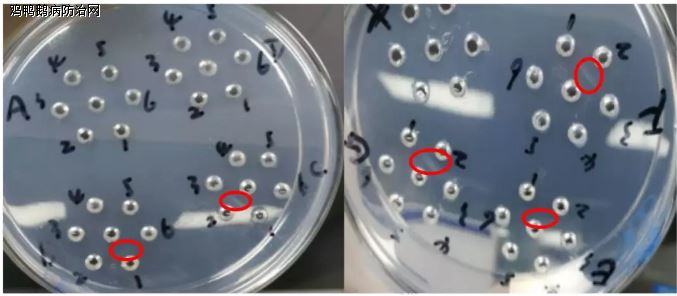

鸡鸭鹅病防治网联合驰骋中兽医研究所共同分享:
作者:张友、李琳、尚辉琴、梁梅兰
鸭传染性浆膜炎是由鸭疫里氏杆菌( Riemerella anatipestifer , RA )引起的一种感染水禽和其他多种鸟类的败血性、渗出性传染病。感染鸭龄集中在2-8周龄,尤其是2-3周龄。自然感染发病率为20%-70%,病死率为5%-80%。该病于1932年首次发生纽约长岛3个鸭场的北京鸭中,1938年在伊利诺斯州的一个商品鸭场发生本病,自1982年郭玉璞在等在国内首次报道北京郊区商品鸭场发生该病以来,该病已逐渐呈全国范围流行。其作为危害全世界养鸭业的主要细菌病,以病鸭高死亡率、低饲料转化率、胴体淘汰、品质下降、和高治疗费等造成巨大经济损失。
一、鸭疫里氏杆菌血清型分型
感染国内鸭群的RA 血清型复杂,1997年以前,国内只有血清1型的报道;1997年之后陆续出现其他血清型的报道,包括血清2、3、4、5、6、7、8、10、11、13、14、15型,不属于1-21血清型的22、23、24、25 血清型,以及多个其他未知血清型。流行病学数据显示,目前国内流行的菌株以1型和2型为主,其次是10型。各血清型之间缺乏有效的交叉保护,且不同血清型、毒株之间毒力差异较大。
二、浆膜炎剖检症状
最明显的大体病变是浆膜表面的纤维素性渗出,以心包、肝脏表面、气囊和脑膜(图1)最为明显;火鸡和其他禽类也有类似的病变。纤维素性气囊炎较常见,胸腔和腹腔气囊均可以发生。脾脏肿大,呈斑驳状。鼻窦内有黏液脓性渗出物,输卵管中有干酪性渗出物。
图1
三、鸭疫里氏杆菌实验室
分离培养、鉴定和分型
1 鸭疫里氏杆菌分离培养
将福建甲地死亡的狮头鹅、半番鸭和乙地死亡的番鸭的脑组织接种TSA,然后放37℃、5%CO2培养箱培养过夜,观察到椭圆形、微凸起、表面光滑、奶油状、直径1-2mm菌落为可疑阳性菌落(如图2)。
图2
2 染色镜检
取单个可疑阳性菌落均匀涂布于加有生理盐水的玻璃片中,然后滴取适量龙胆紫液染色,室温静置30s,冲净和甩干;同样的方法依次加碘溶液、脱色液和沙黄溶液。镜检可以看到单个菌落进行革兰氏染色后,显微镜下观察可见革兰氏阴性,颜色鲜明的细长小杆菌,单个存在,偶见几个排列呈弧形,无芽孢,不能运动(如图3)。
图3
3 PCR鉴定
对可疑阳性菌落提取DNA,进行PCR检测,由核酸电泳凝胶图结果显示该样品中检测到目的片段(如图4),该图为2018年福建甲地鹅场、鸭场和乙地鸭场病料采集样品电泳图,明显扩增出194bp和644bp两条带,条带大小与预期目的片段大小一致,说明甲、乙两地均存在鸭疫里氏杆菌感染。
图4
● 从左至右:M-Marker2000;孔1-2阴性对照;孔3-阳性对照;孔10-12乙地番鸭;13-甲地狮头鹅;15-甲地半番鸭
4 鸭疫里氏杆菌分型
使用浓度分别为8.5%和0.9%的NaCl和琼脂糖倒板,打梅花孔,热稳定抗原加在中央孔,阳性血清加在周围孔。置37℃培养箱过夜,判读结果。由结果可知,对PCR鉴定为阳性的RA进行分型,经琼脂扩散实验得出由半番鸭分离的1株RA为1型,其余4株均为2型(如图5),表明福建甲乙两地感染2型RA居多。
图5
● 从左至右:B-1型;C、E、F、G-2型
四、传染性浆膜炎的防控
考虑到目前国内的实际养殖环境,对于鸭传染性浆膜炎的防控还应该结合药物和疫苗,坚持防重于治、防治一体的原则。由于抗生素的大量使用,RA 耐药性不断增强,不同鸭场分离的菌株,甚至同一鸭场不同批次鸭群分离的菌株对同一种抗生素的敏感性都存在差异。在临床使用药物预防该病时,可以通过交叉轮换用药的方式减少耐药性对防控效果的影响;在发病治疗过程中,最好通过药敏试验确定敏感药物,通过拌料的方式投喂鸭群;如果有必要,可以通过肌肉注射敏感抗生素治疗,但此种方法费时、费力、成本高,在大型养殖场中不可行。
疫苗免疫接种是目前控制鸭传染性浆膜炎的最有效方式。防控鸭传染性浆膜炎仍然是当前乃至今后很长一段时间国内养鸭场的首选。目前,国内有批号的 RA 疫苗有灭活疫苗,包括单价苗(1型)、二价苗(1型+2型)、三价苗(1型+2型+4型,1型+2型+7型)和二联苗(1型鸭传染性浆膜炎、O78型大肠杆菌病二联苗,2型鸭传染性浆膜炎、O78型大肠杆菌病二联苗)。不同地区、不同鸭场流行菌株血清型存在差异,因此定期监测鸭场流行菌株血清型、选择对型疫苗株,是防控RA 的关键。
1 药物防控
1.1 鸭发生鸭疫里氏杆菌病时,治疗方案如下:
a.无抗解决方案:好得快(纯中药制剂)饮水,好得快每瓶兑水300斤+新力爽兑水300斤+驰骋芪贞颗粒兑水300斤,连用3-5天(无抗防治浆膜炎方案)。严重病例可以用清灵+头孢+新六甲或泰灭清混合肌肉注射。
b.特效解决方案:泰灭清或新六甲每瓶兑水300斤+新力爽兑水300斤+驰骋芪贞颗粒兑水300斤,连用3-5天。
c.养殖安(植物提取物)0.75%拌料,连用3-5天,同时添加生命核能(真正的营养补剂)都可取得明显的治疗效果。
d.也可用头孢噻呋钠注射液 2.5-3mg/kg体重肌肉注射,结合大群用药拌料,连续3-5天。
1.2 肉鸭预防保健方案
1-4日龄雏鸭使用恩诺速康(10%恩诺沙星水溶油剂)0.1%拌料+生命核能0.1%拌料。
8-10日龄使用好得快(纯中药制剂饮水300公斤+ 驰骋芪贞颗粒饮水200公斤。
16-18日龄使用普疾宁(氟本尼考可水溶油剂)饮水200公斤水+养殖安0.75%拌料。
26-28日龄使用肠欣安(20%硫酸新霉素水溶油剂)0.06%拌料+养殖安0.15%拌料。
35-37日龄使用芪花益草(植物精油)0.2%拌料+ 生命核能0.1%拌料。
2 疫苗预防

五、无抗预防浆膜炎方法
对于该病的预防,应该充分认识加强饲养管理的重要性,切实落实兽医卫生安全措施。只要饲养管理正确,兽医卫生安全措施得到切实落实的鸭场,浆膜炎的发病率就会很低或者不发生。
1.平时应注意以下几方面:注意减少各种应急因素,由于该病的发生和流行与应急因素密切相关,因此在将雏鸭转舍、舍内迁至舍外饲养时,应注意气候和温度的变化;应注意环境卫生,及时清除粪便,鸭群的饲养密度不能过高,注意通风以及温湿度;应定期进行消毒;如气候变化时,可以加适量的敏感抗菌药物。
2.预防接种是预防该病的有效措施。用鸭传染性浆膜炎三价灭活疫苗对于预防血清1型、2型、7型的传染性浆膜炎具有较好效果。
3.植物精油(芪花益草)防控浆膜炎:定期在饮水中加入芪花益草+驰骋芪贞颗粒,每月连用2-3次 ,每次3-5天即可达到防止浆膜炎的发生。
4.发酵中药(养殖安)防控浆膜炎:当前是鸭黄病毒病、浆膜炎的高发期,为了避免或减少养殖肉鸭肉鹅的朋友,经济少受损失,水禽疫病防控专家魏老师建议:在肉鸭、肉鹅 7-9日龄、18-20日龄、28-30日龄,这三个重要的时间段,准时投喂“驰骋芪贞颗粒+养殖安”即可达到防控黄病毒、浆膜炎、坦布苏病毒的发生和流行。
鸡鸭鹅病防治网为规模化养殖企业(场)提供疫病防控最佳解决方案!!!http://yangzhian880.blog.163.com/
禽病实战专家咨询:13939028068 (技术总监-魏老师 个人 微信:CC-zbs 欢迎交流)博客http://blog.sina.com.cn/u/3862264327
养殖安、驰骋钙、新力爽等产品销售顾问:成龙在路上 13838248089 博客: http://lyrswcl.blog.163.com
来源:鸡鸭鹅病防治网 分享 http://www.jyebfz.com 中兽医 http://www.中兽医.com






发表评论共有0访客发表了评论
暂无评论,快来抢沙发吧!